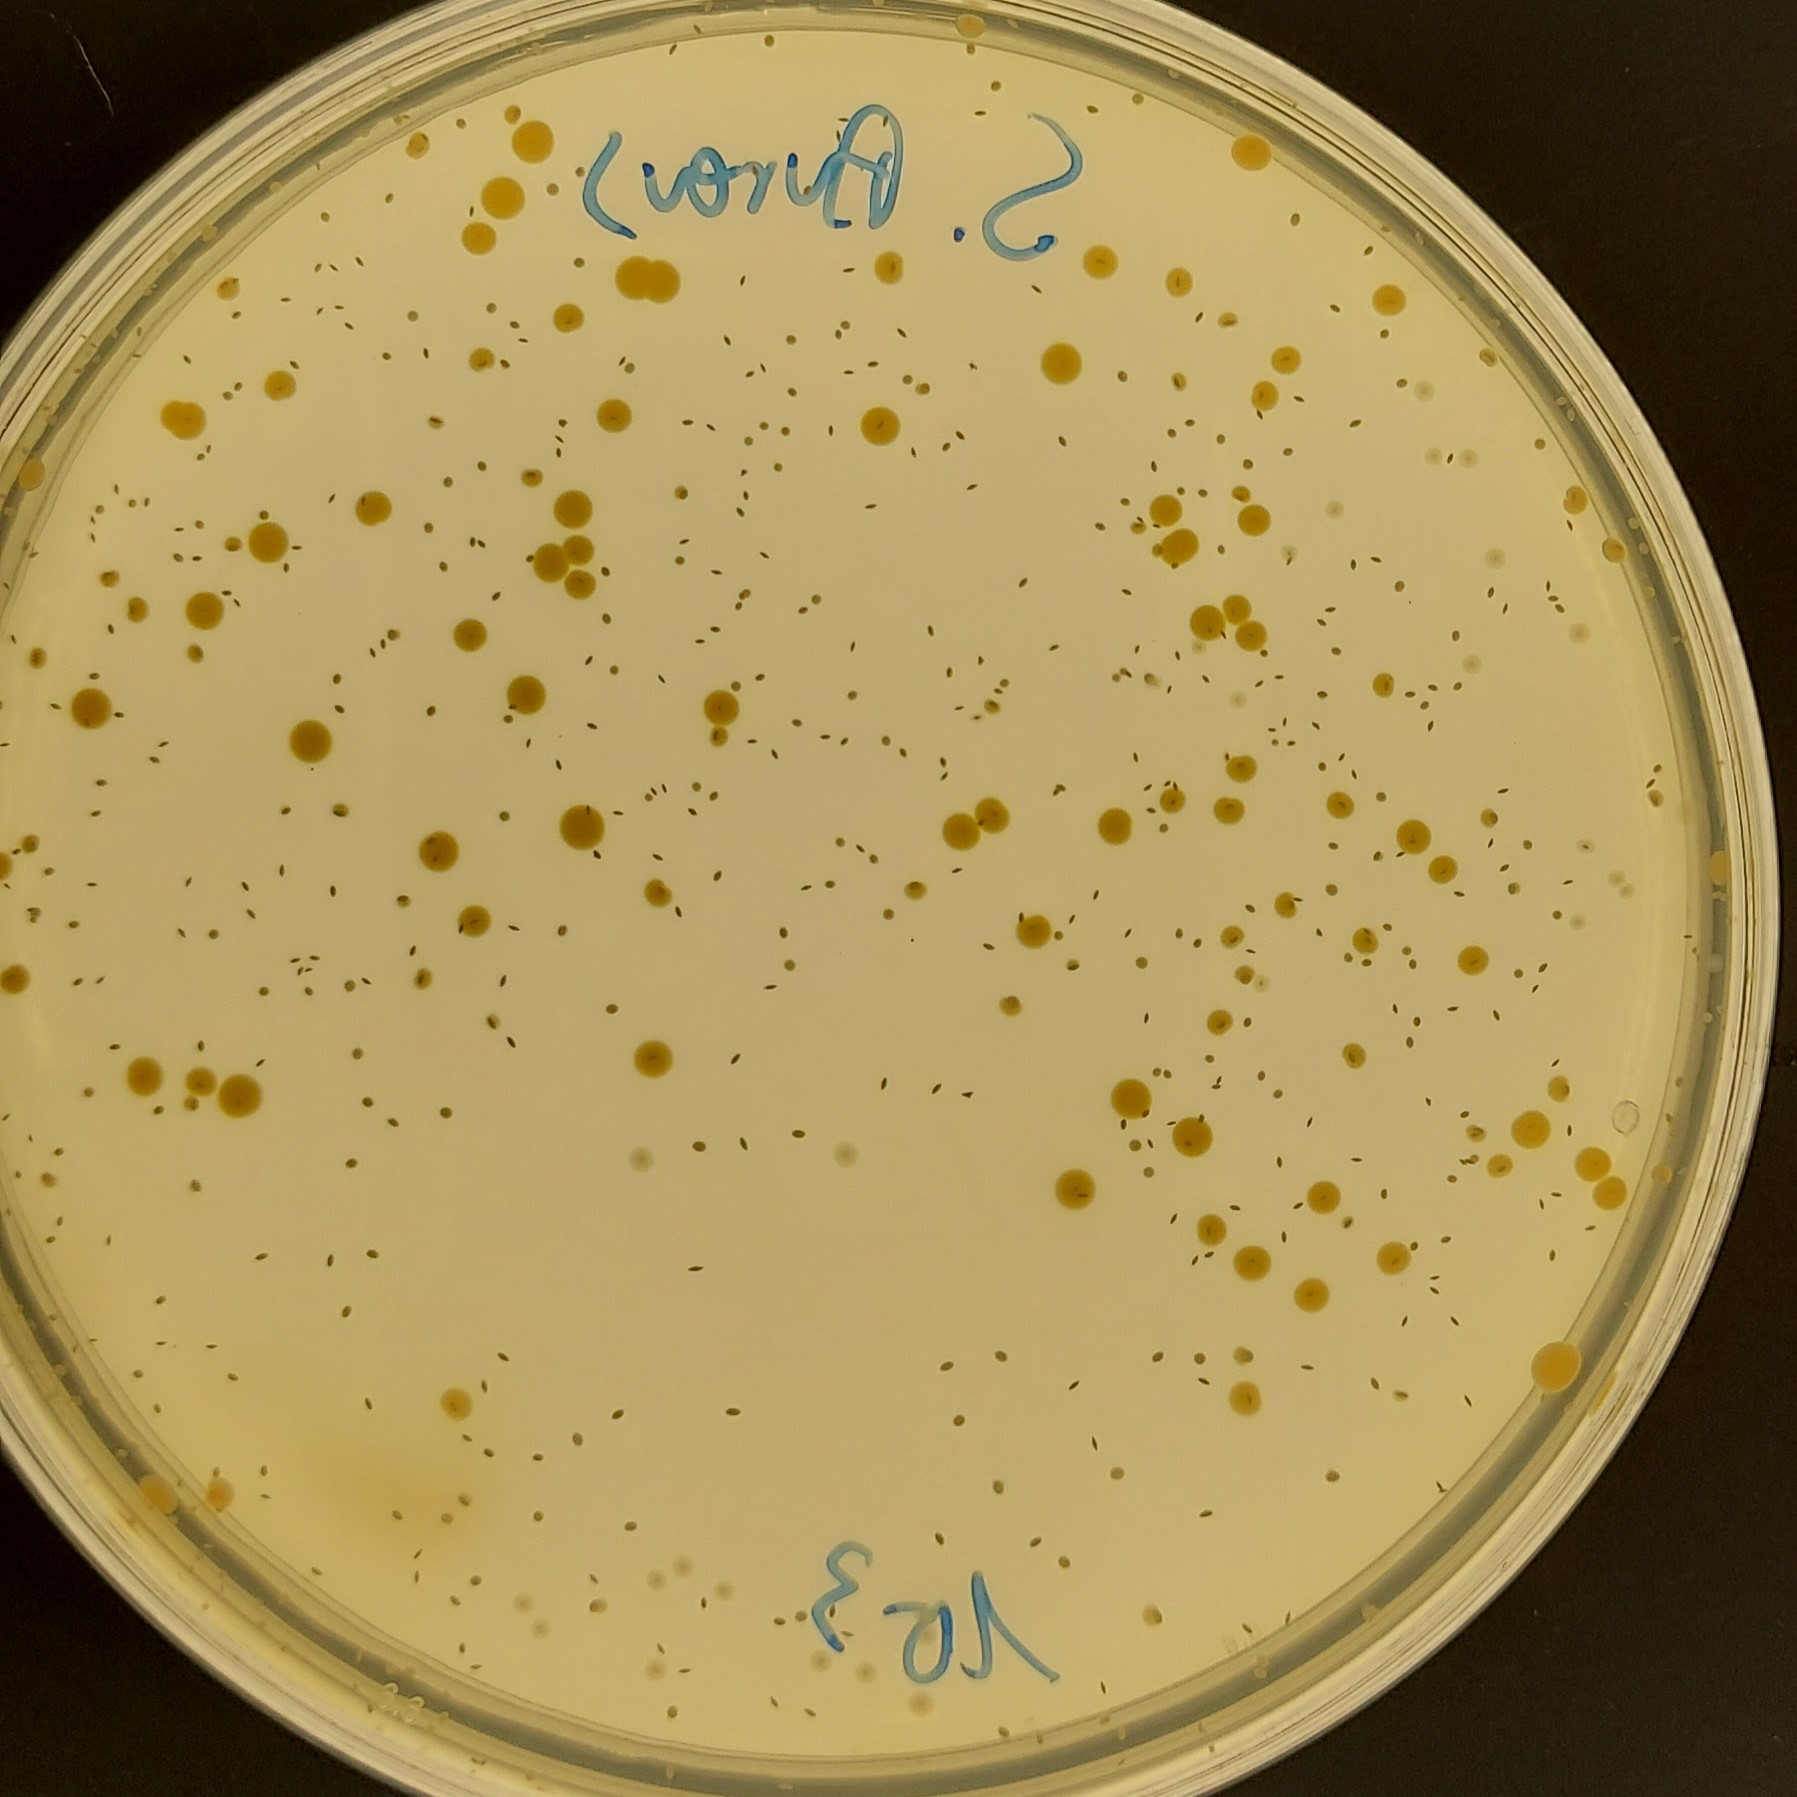

“La iniciativa Frontiers persigue convertir al País Vasco en un referente en el ámbito de las superficies antimicrobianas”
La COVID-19 ha potenciado la necesidad de garantizar mejores prácticas para evitar la propagación de microorganismos, lo que incluye la transmisión a través de superficies contaminadas
El creciente desarrollo de la resistencia de los patógenos a los antibióticos de uso general es un motivo por el que la investigación en superficies, con capacidad de destruir o inhibir la adherencia de bacterias y virus, ha cobrado un renovado interés.
Frontiers 2021, un proyecto colaborativo entre agentes de I+D del País Vasco de diferentes disciplinas, profundiza y avanza en el desarrollo de la investigación estratégica en el campo de los tratamientos de superficie aplicado al ámbito de las biociencias y la salud. La iniciativa persigue que el País Vasco sea un referente en el ámbito de las superficies antimicrobianas.
Para superar las limitaciones actuales, el proyecto abarca las siguientes estrategias y retos:
- Modelo de adhesión y proliferación bacteriana de superficies mediante el desarrollo de un dispositivo capaz de medir la fuerza de adhesión entre microorganismos y substratos, y la capacidad de entender los mecanismos de interacción de las bacterias con las superficies.
- Desarrollo y caracterización de superficies antibacterianas y antivirales inocuas y sostenibles para el control microbiano en superficies.
- Estudio de la efectividad, toxicidad y durabilidad de las superficies.
TECNALIA ha desarrollado nuevas soluciones inocuas y sostenibles para el control microbiano en superficies
Entre estos desarrollos destacan:
- Nuevos recubrimientos de base acuosa de bajo contenido COV’s con eficacia antimicrobiana, incluyendo biocidas biobasados no tóxicos autorizados de conformidad con el Reglamento Europeo de Biocidas 528/2012 y Reglamento CLP (CE nº 1272/2008). Las bacterias contra las que los recubrimientos han sido testados son la E. Coli y S. Aureus con resultado positivo (R>2 en ambos casos). También se ha incorporado un agente auxiliar como agente sinérgico, que permite reducir la cantidad de biocida en el recubrimiento manteniendo la eficacia antibacteriana. Los recubrimientos pueden ser aplicados sobre soporte madera, vidrio o plástico.
- Recubrimientos de capa fina combinando la estructura topográfica superficial y la incorporación de dopantes biocidas, utilizando la tecnología HiPIMS resistente a la acción del entorno; con una durabilidad de la actividad biocida prolongada durante la vida operativa de los componentes.
- Recubrimientos cerámicos e híbridos aplicados mediante tecnología SolGel, finos y transparentes con propiedades biocidas/viricidas y no tóxicas permanentes, en condiciones de servicio
- Nanofibras poliméricas compatibles con sistemas de recubrimiento antivirales y antibacterianos; por ejemplo sistemas de filtración.
- Metodologías para evaluación de la actividad virucida de superficies y materiales según estándares reconocidos internacionalmente.
Agentes vascos que participan en el proyecto
TECNALIA colabora con las principales entidades de I+D de Euskadi para abordar los retos del futuro de la empresa vasca, contribuyendo así a la mejora de su competitividad.
FRONTIERS 2021 ha sido cofinanciado por el Gobierno Vasco a través del Programa Elkartek con nº KK-2021/00124.